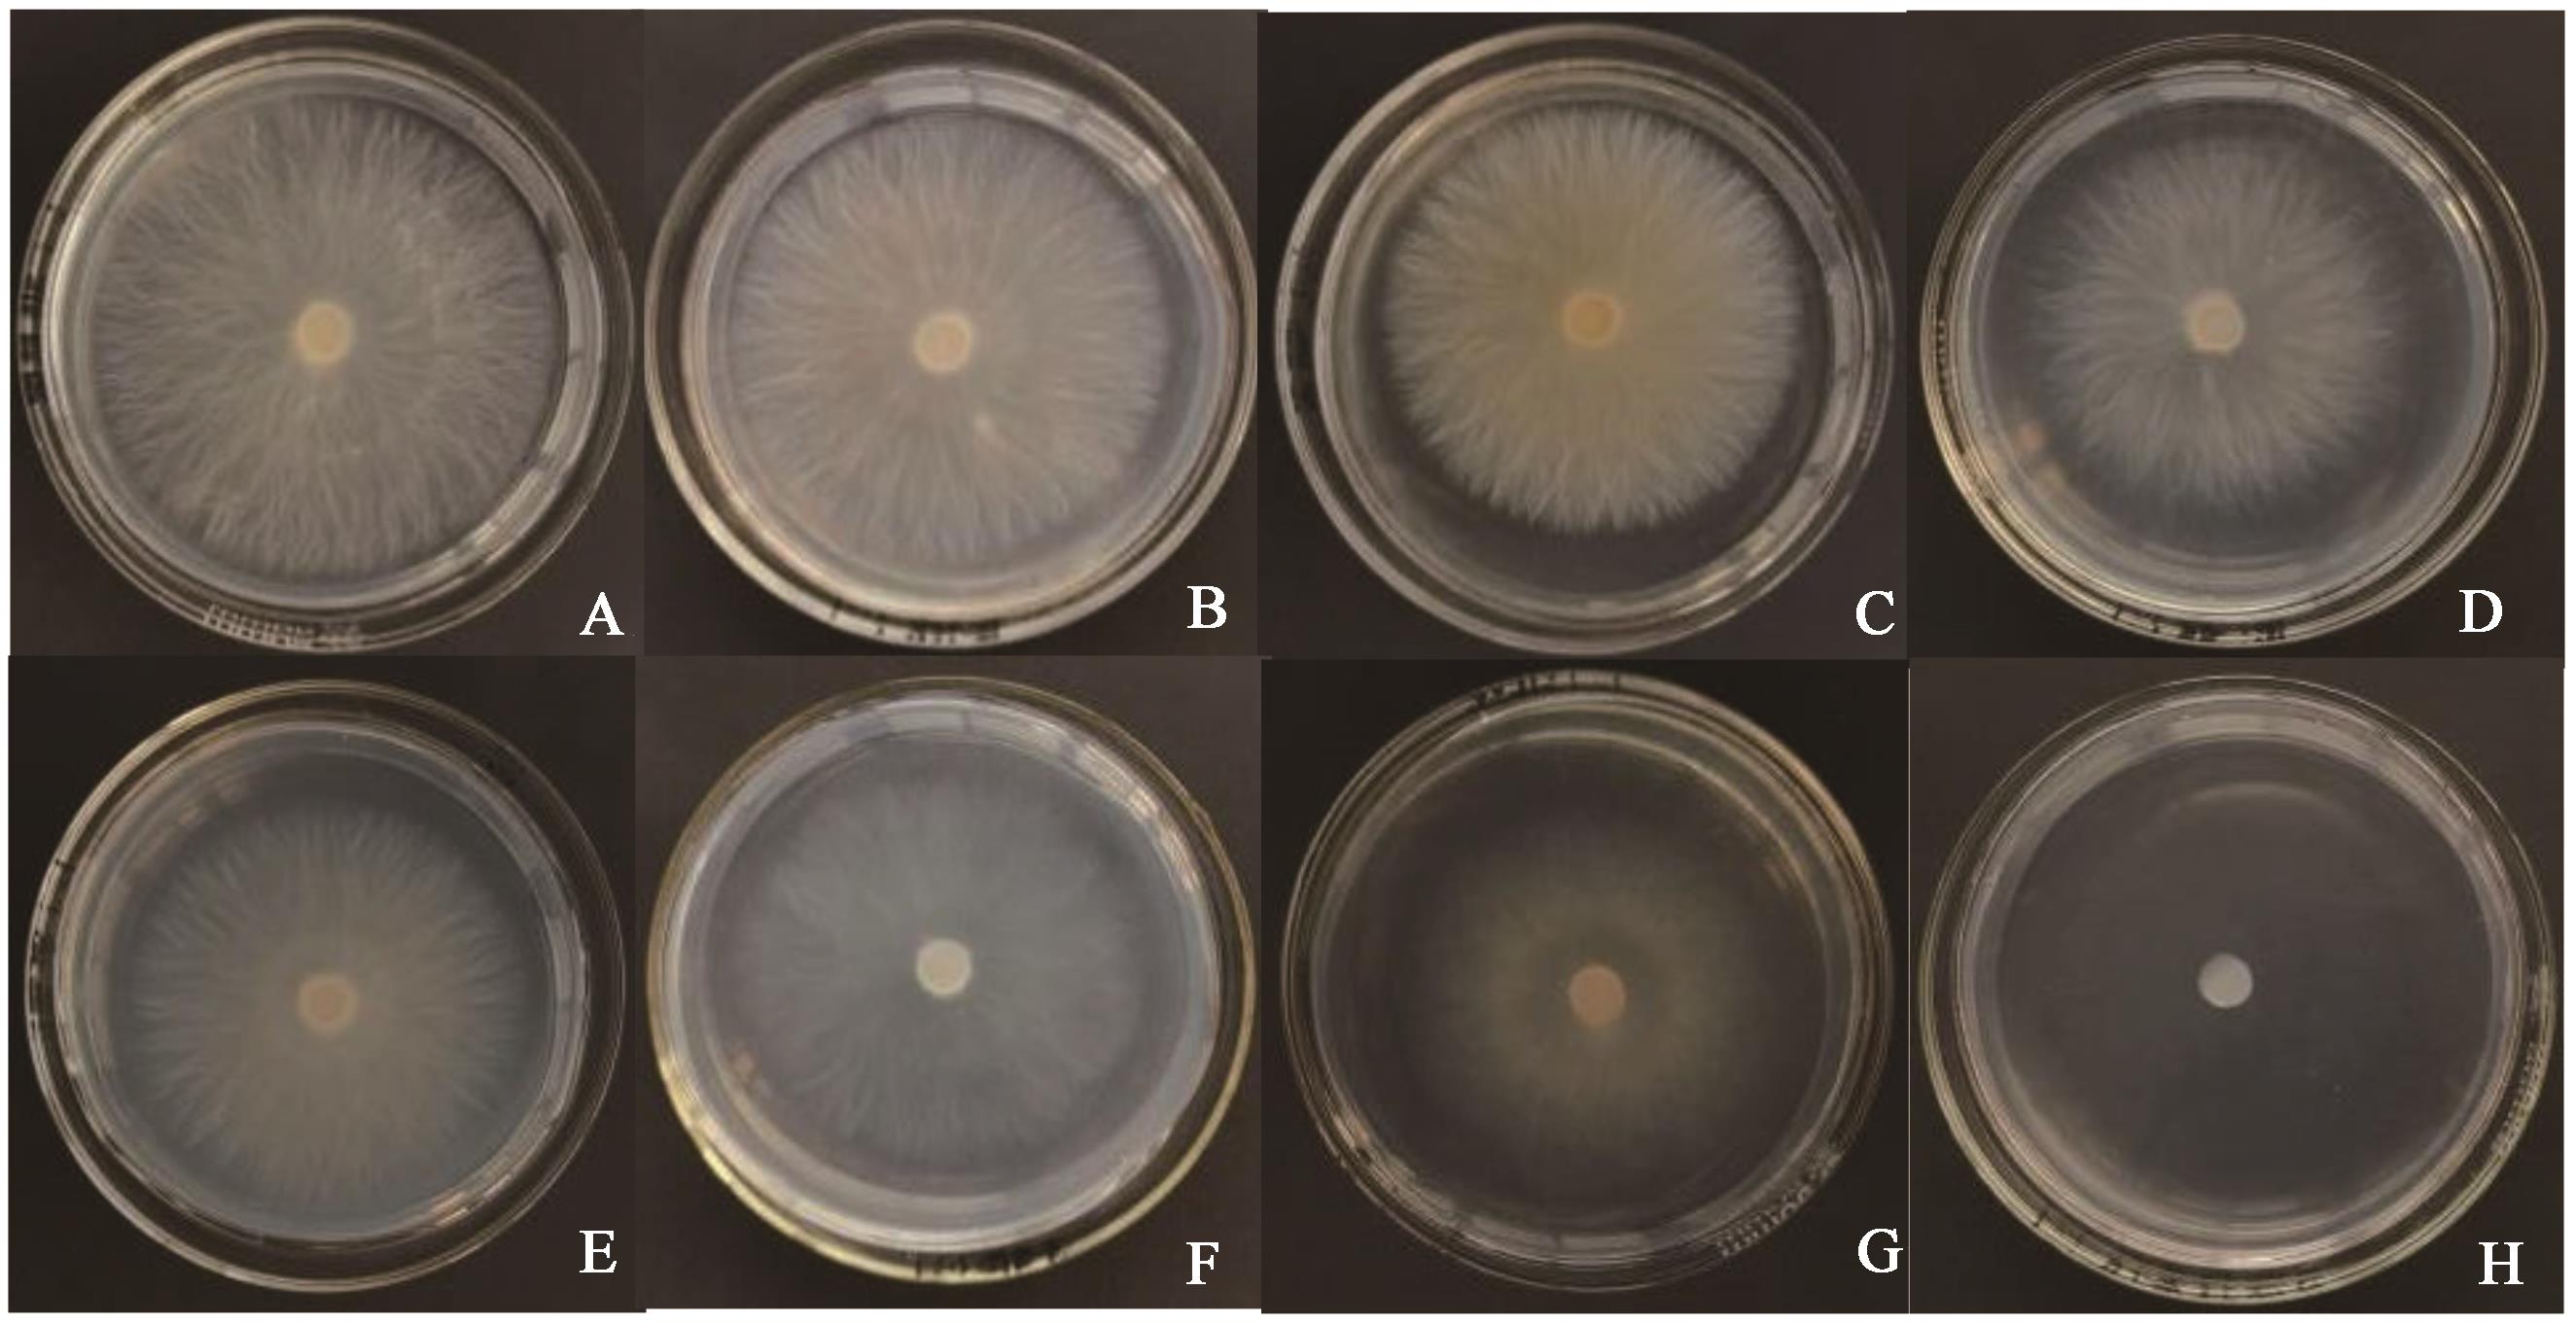
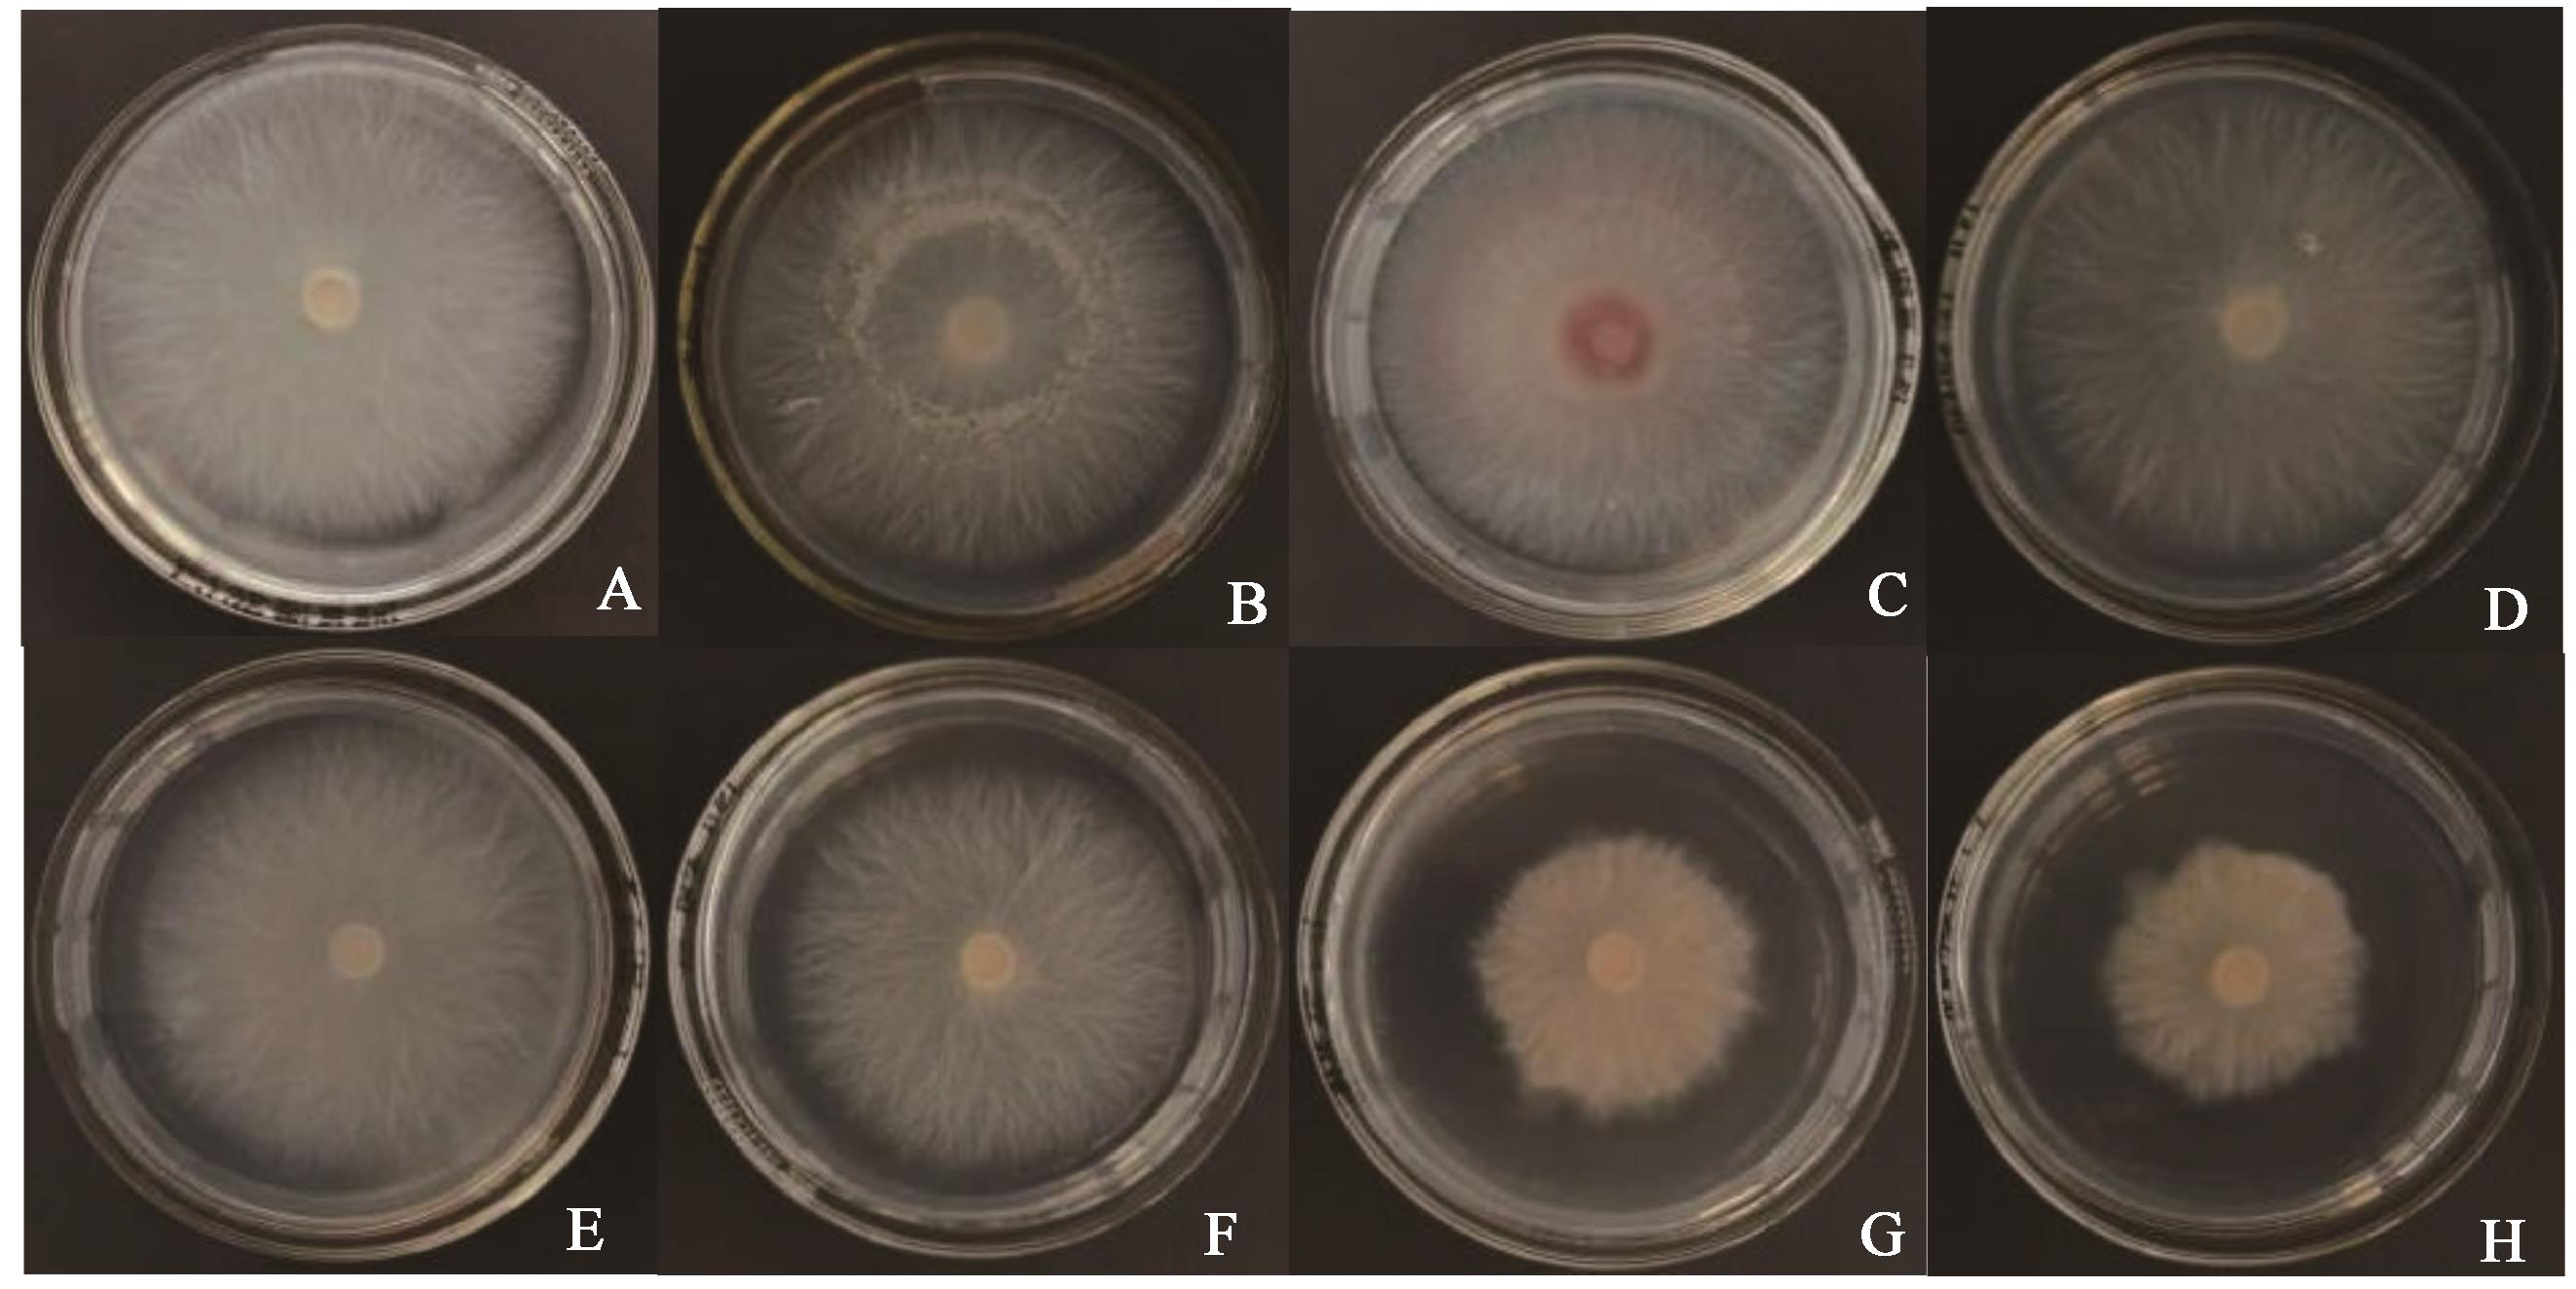
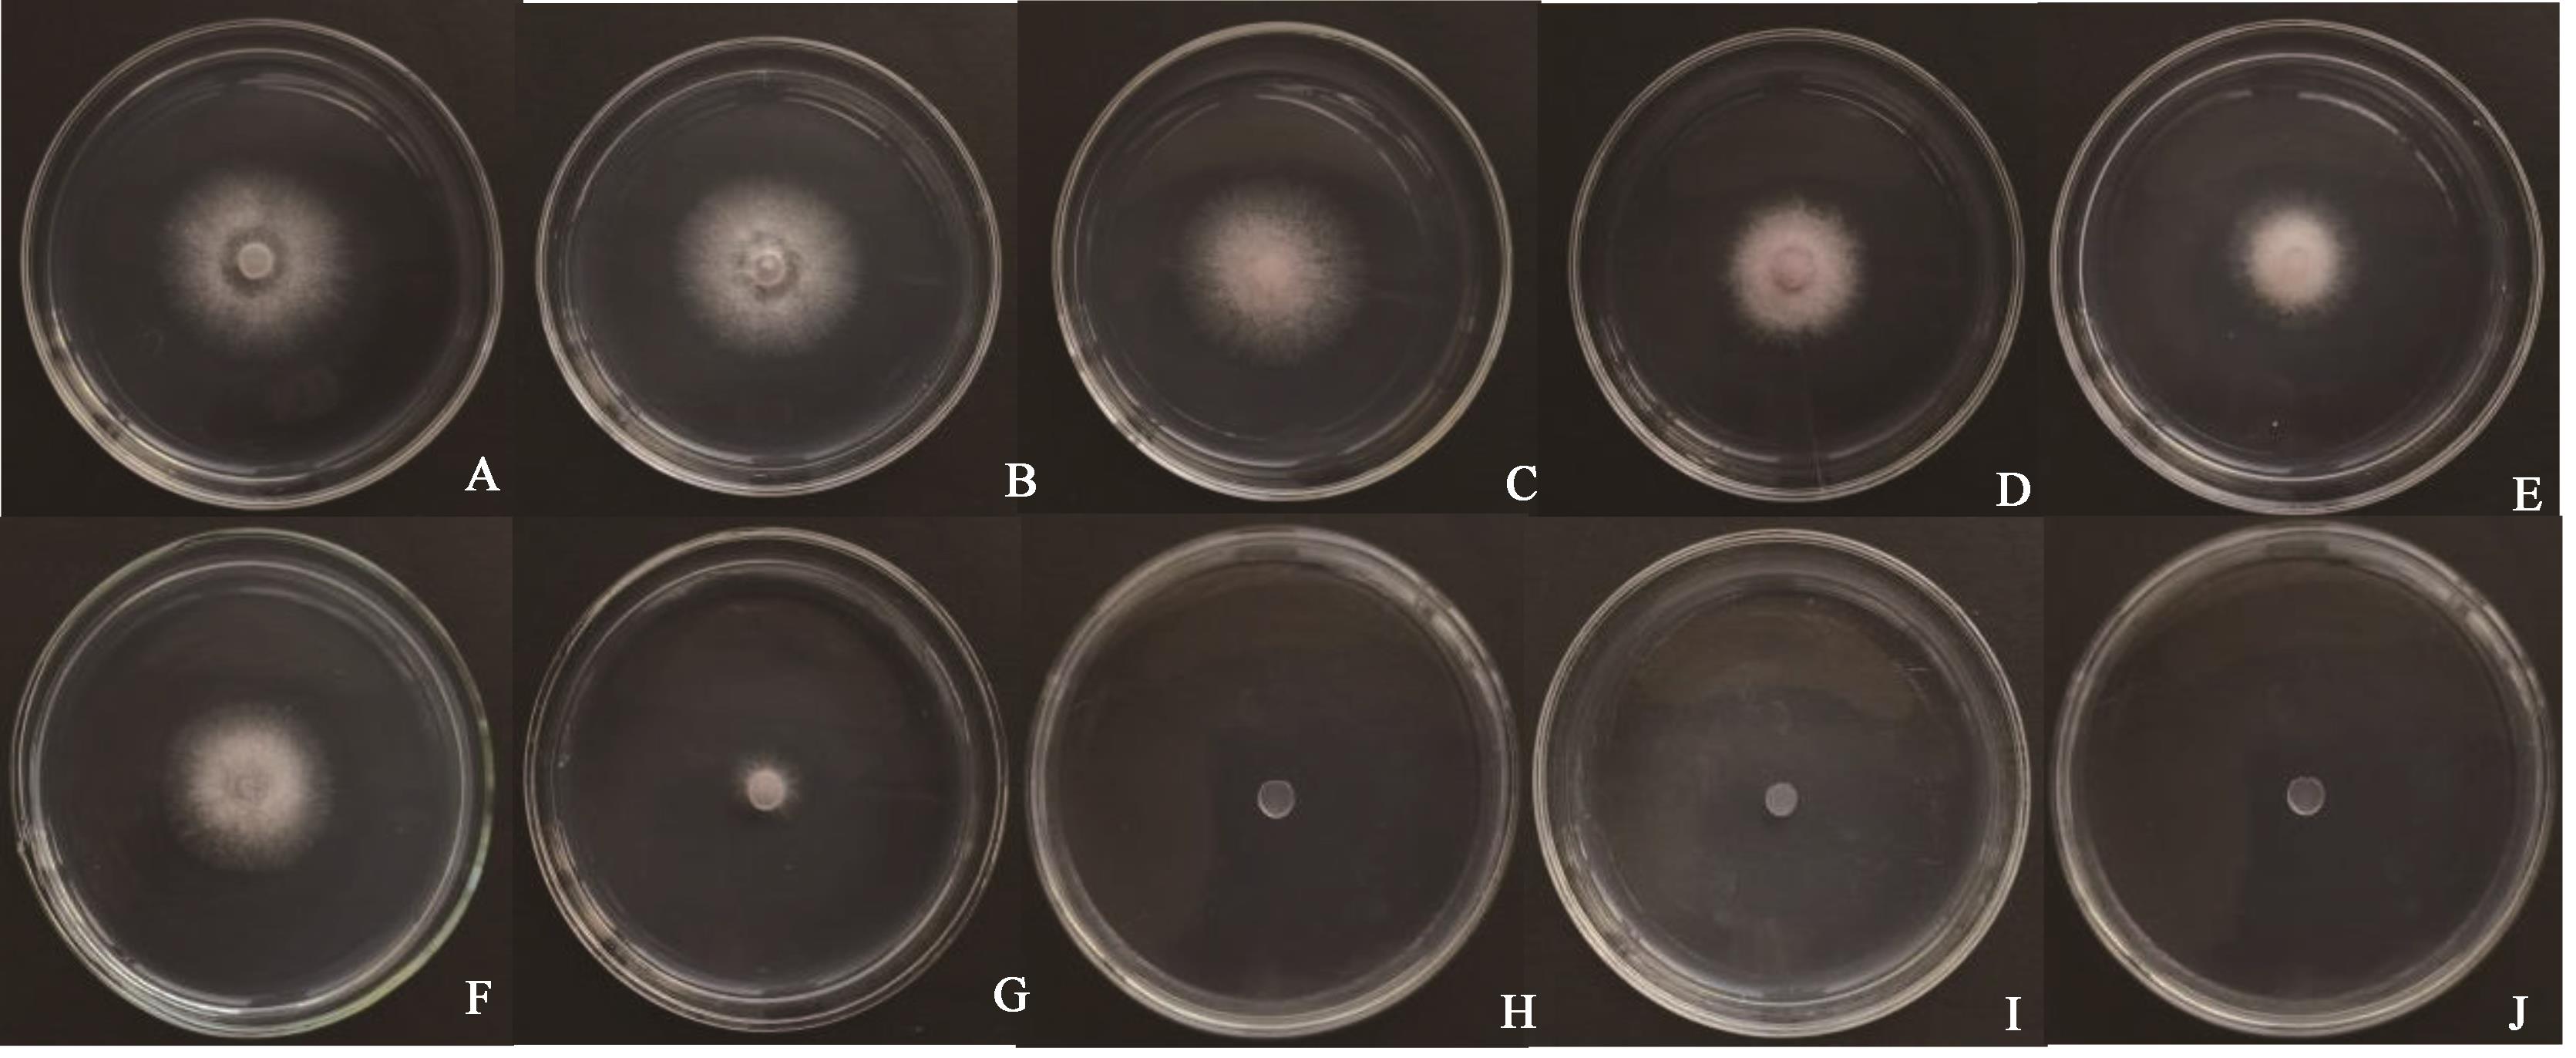

中国农业科技导报 ›› 2022, Vol. 24 ›› Issue (5): 137-144.DOI: 10.13304/j.nykjdb.2021.0468
霍佳欢1( ), 温晓蕾1,2(
), 温晓蕾1,2( ), 李双民3, 冯丽娜1, 兰淑慧1, 董立新4, 郭思柔1, 栗佳宁1, 王建华1, 齐慧霞1(
), 李双民3, 冯丽娜1, 兰淑慧1, 董立新4, 郭思柔1, 栗佳宁1, 王建华1, 齐慧霞1( )
)
收稿日期:2021-06-08
接受日期:2021-09-22
出版日期:2022-05-15
发布日期:2022-06-06
通讯作者:
齐慧霞
作者简介:霍佳欢E-mail:2469634717@qq.com
Jiahuan HUO1( ), Xiaolei WEN1,2(
), Xiaolei WEN1,2( ), Shuangmin LI3, Lina FENG1, Shuhui LAN1, Lixin DONG4, Sirou GUO1, Jianing LI1, Jianhua WANG1, Huixia QI1(
), Shuangmin LI3, Lina FENG1, Shuhui LAN1, Lixin DONG4, Sirou GUO1, Jianing LI1, Jianhua WANG1, Huixia QI1( )
)
Received:2021-06-08
Accepted:2021-09-22
Online:2022-05-15
Published:2022-06-06
Contact:
Huixia QI
摘要:
根腐病严重影响北苍术生产,育苗期至成株期均有发生。为明确引起河北省秦皇岛地区北苍术根腐病病原菌,采用组织分离法获得致病菌菌株,并通过形态学及分子生物学相结合的方法对其进行鉴定,同时分析温度、氮源、碳源对病原菌生长的影响以及菌丝的致死温度。结果表明,引起秦皇岛地区北苍术根腐病的病原菌为尖孢镰刀菌Fusarium oxysporum (MK849925),该病原菌在PDA培养基上菌落近圆形,呈辐射状生长,似绒毛,粉紫色,较干燥。菌丝侧生分支,有隔膜;分生孢子均无色,大型分生孢子呈渐尖型镰刀状,有1~5个分隔,小型分生孢子多为卵形,具1~2个分隔,厚垣孢子圆形、无色。其致病力较强,接种后10 d病部呈深褐色、失水干枯。该病原菌较适宜的生长条件为25 ℃、以酵母浸粉为基础氮源的培养基,培养5 d,菌落直径可达7.17 cm;在不同碳源中,对葡萄糖和蔗糖的利用率较高,而对于可溶性淀粉的利用率较低。菌丝在75 ℃恒温条件下处理10 min后失去生命力。
中图分类号:
霍佳欢, 温晓蕾, 李双民, 冯丽娜, 兰淑慧, 董立新, 郭思柔, 栗佳宁, 王建华, 齐慧霞. 北苍术根腐病病原鉴定及生物学特性研究[J]. 中国农业科技导报, 2022, 24(5): 137-144.
Jiahuan HUO, Xiaolei WEN, Shuangmin LI, Lina FENG, Shuhui LAN, Lixin DONG, Sirou GUO, Jianing LI, Jianhua WANG, Huixia QI. Identification and Biological Characteristics of the Pathogen Causing Root Rot of Atractylodes chinensis[J]. Journal of Agricultural Science and Technology, 2022, 24(5): 137-144.

图5 温度对菌落生长的影响注:图中不同小写字母表示在P<0.05水平差异显著。
Fig. 5 Effect of temperature on colony growthNote:Different lowercase letters in the figure indicate significant differences at P<0.05 level.
碳源 Carbon source | 菌落直径Colony diameter/cm | 平均生长速率 Average growth rate/(cm·d-1) | ||||
|---|---|---|---|---|---|---|
| 1 d | 2 d | 3 d | 4 d | 5 d | ||
| 葡萄糖Glucose | 0.85±0.05 bc | 2.60±0.00 a | 4.17±0.06 b | 5.60±0.00 a | 6.75±0.00 a | 1.350 |
| 蔗糖Sucrose | 0.97±0.06 a | 2.45±0.00 b | 3.97±0.06 c | 5.30±0.00 b | 6.70±0.05 a | 1.340 |
| 果糖 Fructose | 0.82±0.03 c | 2.40±0.00 c | 3.75±0.05 c | 4.93±0.03 c | 6.32±0.03 b | 1.264 |
| 肌醇 Inositol | 0.92±0.03 ab | 2.63±0.03 a | 4.20±0.00 a | 5.57±0.06 a | 6.28±0.03 b | 1.256 |
| 甘露醇 Mannitol | 0.87±0.03 bc | 2.13±0.03 d | 3.50±0.00 d | 4.87±0.00 d | 6.28±0.08 b | 1.256 |
| 木糖Xxylose | 0.72±0.06 d | 2.10±0.00 de | 3.50±0.00 de | 4.78±0.03 e | 6.03±0.03 c | 1.206 |
| 乳糖Lactose | 0.90±0.00 ab | 2.60±0.00 a | 3.77±0.08 b | 4.68±0.03 f | 5.47±0.06 d | 1.094 |
可溶性淀粉 Soluble starch | 0.53±0.03 e | 2.07±0.06 e | 3.23±0.10 e | 4.72±0.03 f | 5.38±0.14 d | 1.076 |
表1 碳源对菌落直径生长的影响
Table 1 Influence of carbon source on the growth of colony diameter
碳源 Carbon source | 菌落直径Colony diameter/cm | 平均生长速率 Average growth rate/(cm·d-1) | ||||
|---|---|---|---|---|---|---|
| 1 d | 2 d | 3 d | 4 d | 5 d | ||
| 葡萄糖Glucose | 0.85±0.05 bc | 2.60±0.00 a | 4.17±0.06 b | 5.60±0.00 a | 6.75±0.00 a | 1.350 |
| 蔗糖Sucrose | 0.97±0.06 a | 2.45±0.00 b | 3.97±0.06 c | 5.30±0.00 b | 6.70±0.05 a | 1.340 |
| 果糖 Fructose | 0.82±0.03 c | 2.40±0.00 c | 3.75±0.05 c | 4.93±0.03 c | 6.32±0.03 b | 1.264 |
| 肌醇 Inositol | 0.92±0.03 ab | 2.63±0.03 a | 4.20±0.00 a | 5.57±0.06 a | 6.28±0.03 b | 1.256 |
| 甘露醇 Mannitol | 0.87±0.03 bc | 2.13±0.03 d | 3.50±0.00 d | 4.87±0.00 d | 6.28±0.08 b | 1.256 |
| 木糖Xxylose | 0.72±0.06 d | 2.10±0.00 de | 3.50±0.00 de | 4.78±0.03 e | 6.03±0.03 c | 1.206 |
| 乳糖Lactose | 0.90±0.00 ab | 2.60±0.00 a | 3.77±0.08 b | 4.68±0.03 f | 5.47±0.06 d | 1.094 |
可溶性淀粉 Soluble starch | 0.53±0.03 e | 2.07±0.06 e | 3.23±0.10 e | 4.72±0.03 f | 5.38±0.14 d | 1.076 |
图6 不同碳源对菌落生长的影响注:A~H分别葡萄糖、蔗糖、果糖、肌醇、甘露醇、木糖、乳糖、可溶性淀粉。
Fig. 6 Effect of different carbon sources on colony growthNote: A~H are glucose, sucrose, fructose, inositol, mannitol, xylose, lactose, soluble starch, respectively.
氮源 Nitrogen source | 菌落直径Colony diameter/cm | 平均生长速率 Average growth rate/(cm·d-1) | ||||
|---|---|---|---|---|---|---|
| 1 d | 2 d | 3 d | 4 d | 5 d | ||
| 酵母浸粉 Yeast extract | 0.77±0.33 d | 2.60±0.00 b | 4.47±0.08 a | 5.67±0.23 a | 7.17±0.08 a | 1.434 |
| 硝酸钠 Sodium nitrate | 0.98±0.03 a | 2.62±0.03 ab | 4.22±0.03 c | 5.53±0.03 ab | 6.80±0.00 b | 1.360 |
| 牛肉膏 Beef extract | 0.83±0.03 c | 2.65±0.00 a | 4.35±0.05 b | 5.40±0.05 bc | 6.77±0.03 b | 1.354 |
| 硝酸钾 Potassium nitrate | 0.77±0.03 d | 2.5±0.00 c | 4.02±0.03 d | 5.35±0.05 c | 6.75±0.05 b | 1.350 |
| 蛋白胨 Peptone | 0.62±0.03 e | 2.35±0.00 d | 3.97±0.03 d | 5.40±0.00 bc | 6.70±0.00 b | 1.340 |
| 尿素 Urea | 0.63±0.03 e | 2.02±0.06 f | 3.33±0.10 f | 4.67±0.08 d | 6.15±0.00 c | 1.230 |
| 氯化铵 Ammonium chloride | 0.95±0.00 ab | 2.37±0.03 d | 3.63±0.08 e | 3.77±0.10 e | 3.68±0.23 d | 0.736 |
| 硫酸铵 Ammonium sulfate | 0.93±0.03 b | 3.05±0.00 e | 3.10±0.00 g | 3.37±0.03 f | 3.53±0.03 d | 0.706 |
表2 氮源对菌落直径生长的影响
Table 2 Influence of nitrogen source on the growth of colony diameter
氮源 Nitrogen source | 菌落直径Colony diameter/cm | 平均生长速率 Average growth rate/(cm·d-1) | ||||
|---|---|---|---|---|---|---|
| 1 d | 2 d | 3 d | 4 d | 5 d | ||
| 酵母浸粉 Yeast extract | 0.77±0.33 d | 2.60±0.00 b | 4.47±0.08 a | 5.67±0.23 a | 7.17±0.08 a | 1.434 |
| 硝酸钠 Sodium nitrate | 0.98±0.03 a | 2.62±0.03 ab | 4.22±0.03 c | 5.53±0.03 ab | 6.80±0.00 b | 1.360 |
| 牛肉膏 Beef extract | 0.83±0.03 c | 2.65±0.00 a | 4.35±0.05 b | 5.40±0.05 bc | 6.77±0.03 b | 1.354 |
| 硝酸钾 Potassium nitrate | 0.77±0.03 d | 2.5±0.00 c | 4.02±0.03 d | 5.35±0.05 c | 6.75±0.05 b | 1.350 |
| 蛋白胨 Peptone | 0.62±0.03 e | 2.35±0.00 d | 3.97±0.03 d | 5.40±0.00 bc | 6.70±0.00 b | 1.340 |
| 尿素 Urea | 0.63±0.03 e | 2.02±0.06 f | 3.33±0.10 f | 4.67±0.08 d | 6.15±0.00 c | 1.230 |
| 氯化铵 Ammonium chloride | 0.95±0.00 ab | 2.37±0.03 d | 3.63±0.08 e | 3.77±0.10 e | 3.68±0.23 d | 0.736 |
| 硫酸铵 Ammonium sulfate | 0.93±0.03 b | 3.05±0.00 e | 3.10±0.00 g | 3.37±0.03 f | 3.53±0.03 d | 0.706 |
图7 不同氮源对菌落生长的影响注:A~H分别为酵母浸粉、硝酸钠、牛肉膏、硝酸钾、蛋白胨、尿素、氯化铵、硫酸铵。
Fig. 7 Effect of different nitrogen sources on colony growthNote: A~H are yeast extract, sodium nitrate, beef extract, potassium nitrate, peptone, urea,ammonium chloride, ammonium sulfate, respectively.
图8 北苍术根腐病菌致死温度注:A~J分别为40、45、50、55、60、65、70、75、80、85℃。
Fig. 8 Lethal temperature of Atractylodes chinensi root rot pathogenNote: A~J are 40, 45, 50, 55, 60, 65, 70, 75, 80, 85℃, respectively.
| 1 | 王义鹏.膜荚黄芪(Astragalus membranaceus)根腐菌分离鉴定及生物学特性研究[D].吉林延吉:延边大学,2018. |
| WANG Y P. Study on isolation, identification and biological characteristics of Astragalus membranaceus of root rot pathogeny [D]. Jilin Yanji: Yanbian University, 2018. | |
| 2 | 孙乐乐,杨永红,刘军凯,等.白及根腐病病原鉴定和生物学特性研究[J].中药材,2013,36(3):341-345. |
| SUN L L, YANG Y H, LIU J K, et al.. Bletilla striata pseudobulb rot pathogen identification and its biological characteristic [J]. J. Chin. Med. Materials, 2013,36(3):341-345. | |
| 3 | 曹兴,刘南南,胡燕佩,等.百合鳞茎腐烂病病原菌的鉴定及生物学特性研究[J].河南农业科学,2018,47(12):96-101. |
| CAO X, LIU N N, HU Y P, et al.. Identification and biological characteristics of the pathogen of Lily bulb rot disease [J]. J. Henan Agric. Sci.,2018,47(12):96-101. | |
| 4 | 高芬,任小霞,王梦亮,等.中草药根腐病及其微生物防治研究进展[J].中国中药杂志,2015,40(21):4122-4126. |
| GAO F, REN X X, WANG M L, et al.. Research progress in root rot diseases of Chinese herbal medicine and control strategy by antagonistic microorganisms [J]. Chin. J. Chin. Mater. Med., 2015,40(21):4122-4126. | |
| 5 | 孔琼,袁盛勇,郭建伟,等.铁皮石斛根腐病病原菌鉴定及生物学特性研究[J].中药材,2018,41(7):1566-1570. |
| KONG Q, YUAN S Y, GUO J W, et al.. Pathogen identification and biological characteristics of root-rot disease in Dendrobium officinale [J]. J. Chin. Med. Materials,2018,41(7):1566-1570. | |
| 6 | 刘亚亚,陈垣,郭凤霞,等.掌叶大黄根腐病病原菌的分离与鉴定[J].草业学报,2011,20(1):199-205. |
| LIU Y Y, CHEN Y, GUO F X, et al.. Isolation and identification of pathogens causing root rot of Rheum palmatum [J]. Acta Pratac. Sin., 2011,20(1):199-205. | |
| 7 | 张晋豪,杨俊,姬广海,等.云南三七根腐病病原细菌的鉴定[J].南方农业学报,2020,51(3):586-592. |
| ZHANG J H, YANG J, JI G H, et al.. Bacterial pathogen identification of Panax notoginseng root rot in Yunnan province [J]. J. Southern Agric., 2020,51(3):586-592. | |
| 8 | 韩凤,肖忠,李巧玲,等.不同类型苍术主要遗传性状的比较研究[J].中国野生植物资源,2020,39(5):1-8. |
| HAN F, XIAO Z, LI Q L, et al.. Constrastive study on main genetic characters of different types of Atractylodes lancea [J]. Chin. Wild Plant Resour.,2020,39(5):1-8. | |
| 9 | 徐海娇,葛昕欣,周如军,等.辽宁省北苍术病害调查及种类鉴定[J].植物保护,2016,42(6):143-148, 153. |
| XU H J, GE X X, ZHOU R J, et al.. The survey and identification disease on Atractylodes chinensis in Liaoning province [J]. Plant Protection, 2016,42(6):143-148, 153. | |
| 10 | 崔海洋,温晓蕾,冯丽娜,等.秦皇岛市北苍术三种叶部病害病原菌的鉴定[J].植物病理学报,2021,51(5):807-812. |
| CUI H Y, WEN X L, FENG L N, et al.. Identification of fungal pathogens of three foliar diseases in atractylodes lanceolata in Qinhuangdao City [J]. Acta Phytopathol. Sin., 2020,51(5):807-812. | |
| 11 | SUN W M, WEN X L, QIH X, et al.. First Report of anthracnose of Atractylodes chinensis caused by Colletotrichum chlorophyti in China [J]. Plant Dis., 2018,103 (4):764. |
| 12 | 方中达.植病研究方法[M]. 第三版.北京:中国农业出版社出版,1998:122-125. |
| 13 | 刘伟,张勤德,王多文,等.枸杞新病害叶枯病症状表现及病原菌鉴定[J].北方园艺,2018(12):141-145. |
| LIU W, ZHANG Q D, WANG D W, et al.. Disease symptom and pathogen identifaction of Lycium baraum leaf blight disease [J]. Northern Hortic., 2018(12):141-145. | |
| 14 | 陆家云.植物病原真菌学[M].北京:中国农业出版社出版,2001,436-441. |
| 15 | 张秀,刘蕾,王辉,等.山东省番茄尖孢镰刀菌的分离及鉴定[J].山东农业科学,2019,51(12):78-81. |
| ZHAMG X, LIU L, WANG H, et al.. Isolation and identification of tomato Fusarium oxysporum in Shandong province [J]. Shandong Agric. Sci., 2019,51(12):78-81. | |
| 16 | 王铁霖,郭兰萍,张燕,等.苍术常见病害的病原、发病规律及综合防治[J].中国中药杂 志,2016,41(13):2411-2415. |
| WANG T L, GUO L P, ZHANG Y, et al.. Pathogen identification,regularity of development and control measures of diseases on Atractylodes lancea [J]. Chin. J. Chin. Mater. Med., 2016, 41(13):2411-2415. | |
| 17 | 宋嘉伟.山核桃根腐病病原菌鉴定及其系统发育分析[D].杭州:浙江农林大学, 2019. |
| SONG J W. Identifaction and phylogeny of the pathogens from Carya cathayensis root-rot [D]. Hangzhou: Zhejiang A&F University dissertation for the Degree of Master, 2019. | |
| 18 | 程相瑞,李丙雪,卢靖天,等.矮化核桃枝枯病病原菌的形态与分子鉴定[J].植物保护,2019,45(3):78-82, 133. |
| CHANG X R, LI B X, LU J T, et al.. Morphologicai and molecular idenyifaction of the pathogen of dwarfing walnut branch blight [J]. Plant Protection,2019,45(3):78-82, 133. | |
| 19 | 张鸿雁,任勇洋,曹新宇,等.人参锈腐病病原菌鉴定及生物学特性研究[J].北方园艺,2015(19):118-122. |
| ZHANG H Y, REN Y Y, CAO X Y, et al.. Study on pathogen identification and biological characterstics of ginseng rust rot [J]. Northern Hortic., 2015(19):118-122. | |
| 20 | 高晓敏,王琚钢,马立国,等.尖孢镰刀菌致病机理和化感作用研究进展[J].微生物学通报,2014,41(10):2143-2148. |
| GAO X M, WANG J G, MA L G, et al.. Research advances on the mechanism of pathogenesis and allelopathy of Fusarium oxysporium [J]. Microbiol. China, 2014,41(10):2143-2148. | |
| 21 | 文增叶,李定华,代梦瑶,等.三七根腐病病原菌尖孢镰刀菌的生物学特性分析[J].中药材,2019,42(9):1978-1984. |
| WEN Z Y, LI D H, DAI M Y, et al.. Biological characteristics of Fusarium oxysporum,a pathogen of Panax notoginseng root rot [J]. J. Chin. Med. Materials, 2019,42(9):1978-1984. | |
| 22 | 尹乐斌,李立才,孟庆霞,等.龙牙百合腐败菌的分离鉴定、生物学特性及抑制剂筛选[J].食品与机械,2019,35(6):79-84. |
| YIN L B, LI L C, MENG Q X, et al.. Isolation,identifaction,biological characterisin of spoilage strains in Lilum brownii and screening of the relative inhibitors [J]. Food Machinery,2019,35(6):79-84. | |
| 23 | 耿丽华,王建设,马建,等.一种甜瓜新症状病害的病原鉴定及其生物学特性[J].中国瓜菜,2021,34(3):15-20. |
| GENG L H, WANG J S, MA J, et al.. Identification and biological characteristics of the pathogen causing a new symptom disease of melon [J]. China Cucur. Veget., 2021,34(3):15-20. |
| [1] | 杨艺帅, 谭琳, 牛丽, 舒坪, 史子涵, 方洁, 胡秋龙. 茶树根腐病菌生物学特征及室内药剂筛选[J]. 中国农业科技导报, 2025, 27(7): 133-141. |
| [2] | 杨冰. 大豆疫霉菌的致病机制及寄主分子响应和防控方法研究进展[J]. 中国农业科技导报, 2025, 27(3): 133-142. |
| [3] | 母时风, 温晓蕾, 冯丽娜, 赵德轩, 高素红, 高朋, 齐慧霞. 一种引起板栗内腐病的果生炭疽菌鉴定及其生物学特性[J]. 中国农业科技导报, 2024, 26(9): 122-128. |
| [4] | 杨娅琳, 吴峰婧琳, 陈健鑫, 武自强, 刘丽, 张东华, 马焕成, 伍建榕. 油茶根腐病根际土壤、根系内真菌群落结构和多样性分析[J]. 中国农业科技导报, 2024, 26(7): 121-135. |
| [5] | 刘崇涛, 李同, 李洋洋, 刘壮壮, 蔡阳扬, 宋建超, 张万通, 尚斌, 陶秀萍. 紫外线对栽培营养废液的抑菌效应及营养成分影响研究[J]. 中国农业科技导报, 2024, 26(7): 166-173. |
| [6] | 卢登洋, 童盼盼, 闫敏, 鲍荆凯, 刘鸣哲, 夏怡蕾, 吴翠云. 库尔勒香梨大果芽变的鉴定与评价[J]. 中国农业科技导报, 2024, 26(5): 52-64. |
| [7] | 谢波艳, 孔丽静, 张煜彬, 孙成龙, 赵思源, 张明慧, 范圣此, 向增旭, 郑金双. 北苍术种质遗传多样性及群体结构分析[J]. 中国农业科技导报, 2024, 26(12): 39-49. |
| [8] | 方泰军, 侯璐, 白露超. 柴达木地区患根腐病枸杞根际土壤微生物多样性分析[J]. 中国农业科技导报, 2024, 26(1): 133-139. |
| [9] | 周世莹, 刘晏辰, 张洋, 杨雪松, 关伟军, 高扬. 大耳白兔骨髓间充质干细胞的分离培养与生物学鉴定[J]. 中国农业科技导报, 2023, 25(8): 96-105. |
| [10] | 王鑫慈, 李军乔, 李晨芹, 田甜, 曲俊儒. 一株乳突赤壳属蕨麻致病菌的鉴定及生物学特性[J]. 中国农业科技导报, 2023, 25(5): 87-95. |
| [11] | 郑童童, 杨雯迪, 王宁, 马俊杰, 刘龙, 郭庆元. 小麦叶枯病病原菌的形态学与多基因系统学鉴定[J]. 中国农业科技导报, 2023, 25(2): 111-118. |
| [12] | 许鑫, 孟昆, 蔡红英, 杨培龙, 蒋显仁. 乳酸菌在猪生产中的应用研究进展[J]. 中国农业科技导报, 2023, 25(2): 19-26. |
| [13] | 杨克泽, 吴芳, 魏玉杰, 汪亮芳, 常浩, 吴之涛, 杨宪忠. 河西冷凉地区芍药根腐病病原鉴定及室内药剂筛选[J]. 中国农业科技导报, 2023, 25(10): 144-151. |
| [14] | 孙华, 郭宁, 郑晓娟, 石洁, 张立荣, 闫红飞. 玉米穗腐病病原菌新知镰孢的鉴定及其生物学特性分析[J]. 中国农业科技导报, 2022, 24(2): 145-151. |
| [15] | 张娜娜§, 李双民§, 温晓蕾, 冯丽娜, 王俊凤, 杨文杰, 霍佳欢, 兰淑慧, 孙伟明, 齐慧霞. 板栗红粉病病原菌鉴定及其生物学特性研究[J]. 中国农业科技导报, 2021, 23(7): 145-152. |
| 阅读次数 | ||||||
|
全文 |
|
|||||
|
摘要 |
|
|||||